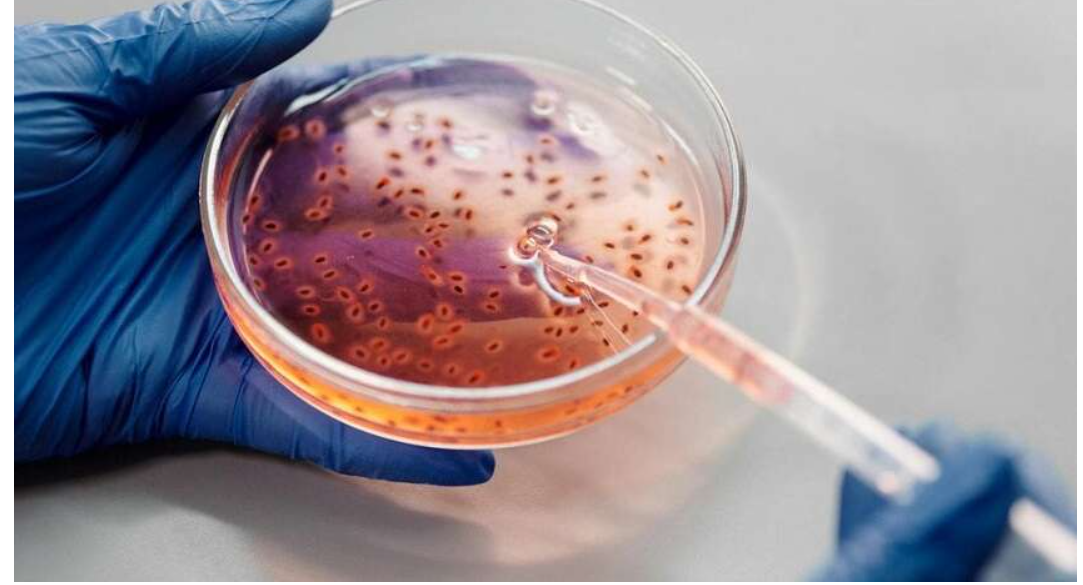

ВООЗ б'є на сполох через небезпечну "тиху пандемію": щороку помирають мільйони
ВООЗ б'є на сполох через небезпечну "тиху пандемію": щороку помирають мільйони
ВООЗ попереджає: щорічно понад мільйон людей помирає через антибіотикорезистентні бактерії, а до 2050 року кількість смертей може подвоїтися.
Всесвітня організація охорони здоров’я (ВООЗ) опублікувала новий звіт, у якому попереджає про глобальну загрозу, пов’язану з антибіотикорезистентними бактеріями.
Щорічно вони стають причиною більше ніж мільйона смертей, а до 2050 року ця цифра може зрости майже удвічі — до 1,9 мільйона. Фото: з відкритих джерел Як повідомляє The Telegraph, розробка нових антибіотиків йде дуже повільно. Якщо у 2023 році у стадії клінічних випробувань перебувало 97 препаратів, то зараз їх залишилось лише 90. З них лише 15 вважаються дійсно інноваційними, тоді як більшість — це лише модифікації вже існуючих ліків. Частина проектів була припинена через недостатню ефективність.
ВООЗ наголошує, що надмірне застосування антибіотиків сприяє формуванню резистентних штамів бактерій, які майже не піддаються лікуванню. Яскравим прикладом є MRSA — метицилін-резистентний золотистий стафілокок.
У 2021 році ця інфекція забрала близько 130 тисяч життів у Великій Британії, що удвічі перевищує показники 1990 року. Система розробки нових антибіотиків нині перебуває у кризі через брак фінансування та недостатню кількість справді ефективних інновацій. З десяти з п’ятнадцяти потенційно нових препаратів лише частина пройшла перевірку на відсутність перехресної резистентності — явища, коли стійкість до одного антибіотика знижує дію іншого. Також гостро стоїть питання відсутності сучасних ліків для дітей і пероральних форм препаратів для амбулаторного лікування хронічних інфекцій, наприклад, сечовивідних шляхів. Незважаючи на виклики, науковці покладають надії на штучний інтелект. З його допомогою вже створено два нові антибіотики, ефективні проти MRSA і гонореї.
Однак без відповідного фінансування ці розробки не зможуть пройти клінічні випробування. У ВООЗ підкреслюють, що лише спільні зусилля урядів і фармацевтичних компаній можуть зупинити "тиху пандемію" антибіотикорезистентності. Інакше поширення супербактерій перевищить темпи появи нових ліків, що може призвести до серйозної глобальної кризи у медицині. Портал "Коментарі" писав, що досвідчені кухарі знають, що навіть найсмачніші пельмені можуть втратити свій вигляд і текстуру, якщо їх неправильно приготувати. Один із найпростіших і водночас ефективних способів зберегти пельмені цілими, соковитими та апетитними – це додати у воду трохи рослинної олії. Цей нехитрий трюк допомагає уникнути найпоширеніших проблем — злипання пельменів і розривів тіста під час варіння.
Водій електроскутера, який на смерть збив жінку у Миколаєві, отримав 3 роки в'язниці
У центрі Миколаєва зарості чортополоху цвітуть пишним цвітом: «Миколаївські парки» не вживають жодних заходів
В Одесі російський дрон влетів у квартиру на 11 поверсі (відео)
На Одещині водій BMW, який перебував у розшуку, збив прикордонника під час спроби втечі (відео)
На Одещині чоловіка придавило бетонною плитою в покинутій будівлі (відео)
«Амур. Дубль два» - нова робота миколаївської художниці на тему «втечі із міськвиконкому» (фото, відео)
«Обличчя театру»: яскраві театральні особистості у роботах Ярослава Туріва (фото, відео)
Музика від серця та для душі: Еліна Образцова зіграла авторський концерт (фото, відео)
«Світло всередині нас»: Хореографічний колектив «Карамель» показав ювілейну програму (фото, видео)













